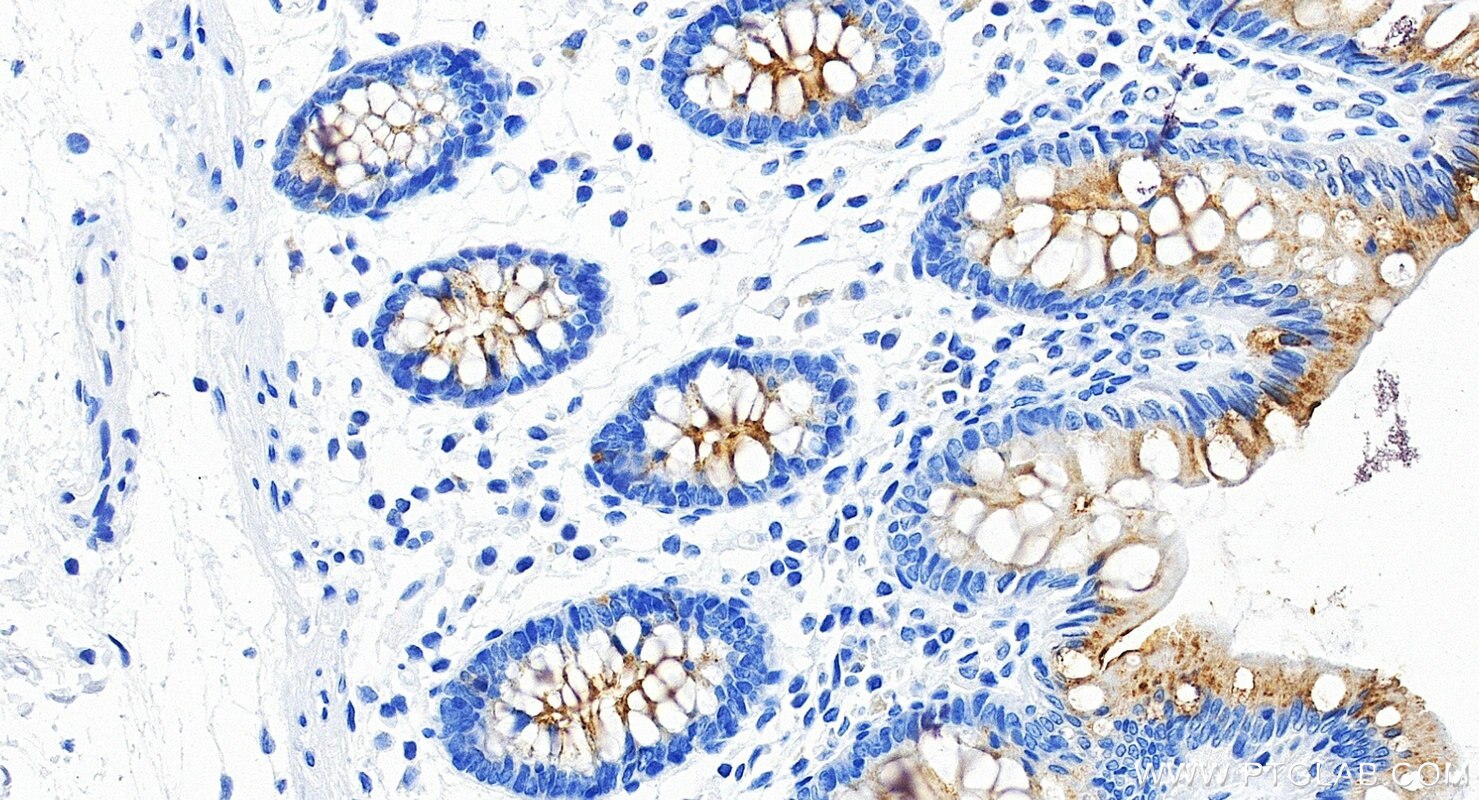
Immunohistochemistry (IHC) staining of human colon tissue using MUC13 Recombinant monoclonal antibody (87107-2-RR)

Product Information
87107-2-PBS targets MUC13 as part of a matched antibody pair:
MP02867-1: 87107-2-PBS capture and 87107-1-PBS detection (validated in Cytometric bead array)
Unconjugated rabbit recombinant monoclonal antibody in PBS only (BSA and azide free) storage buffer at a concentration of 1 mg/mL, ready for conjugation. Created using Proteintech’s proprietary in-house recombinant technology. Recombinant production enables unrivalled batch-to-batch consistency, easy scale-up, and future security of supply.
This conjugation ready format makes antibodies ideal for use in many applications including: ELISAs, multiplex assays requiring matched pairs, mass cytometry, and multiplex imaging applications.Antibody use should be optimized by the end user for each application and assay.
| Tested Reactivity | human |
| Host / Isotype | Rabbit / IgG |
| Class | Recombinant |
| Type | Antibody |
| Immunogen |
CatNo: Eg6586 Product name: Recombinant Human MUC13 protein (rFc Tag) Source: mammalian cells-derived, V37 Tag: C-rFc Domain: 19-421 aa of NM_033049.4 Sequence: TNQGNSADAVTTTETATSGPTVAAADTTETNFPETASTTANTPSFPTATSPAPPIISTHSSSTIPTPAPPIISTHSSSTIPIPTAADSESTTNVNSLATSDIITASSPNDGLITMVPSETQSNNEMSPTTEDNQSSGPPTGTALLETSTLNSTGPSNPCQDDPCADNSLCVKLHNTSFCLCLEGYYYNSSTCKKGKVFPGKISVTVSETFDPEEKHSMAYQDLHSEITSLFKDVFGTSVYGQTVILTVSTSLSPRSEMRADDKFVNVTIVTILAETTSDNEKTVTEKINKAIRSSSSNFLNYDLTLRCDYYGCNQTADDCLNGLACDCKSDLQRPNPQSPFCVASSLKCPDACNAQHKQCLIKKSGGAPECACVPGYQEDANGNCQKCAFGYSGLDCKDKFQL Predict reactive species |
| Full Name | mucin 13, cell surface associated |
| Calculated Molecular Weight | 55 kDa |
| Observed Molecular Weight | 120 kDa |
| GenBank Accession Number | NM_033049.4 |
| Gene Symbol | MUC13 |
| Gene ID (NCBI) | 56667 |
| Conjugate | Unconjugated |
| Form | Liquid |
| Purification Method | Protein A purification |
| UNIPROT ID | Q9H3R2 |
| Storage Buffer | PBS only, pH 7.3. |
| Storage Conditions | Store at -80°C. |
Background Information
Mucins (MUC) are highly glycosylated proteins that are abundantly expressed in mammalian epithelial cells. Mucin 13 (MUC13) is a member of the transmembrane glycoprotein mucins, which are normally expressed in the large intestine, trachea, kidney, small intestine, and gastric epithelium (PMID: 22027689). MUC13 is involved in the tumorigenesis of multiple malignancies, including pancreatic cancer, colorectal cancer, renal cancer, and lung cancer (PMID: 22027689; PMID: 31427737; PMID: 28205224; PMID: 34966453).